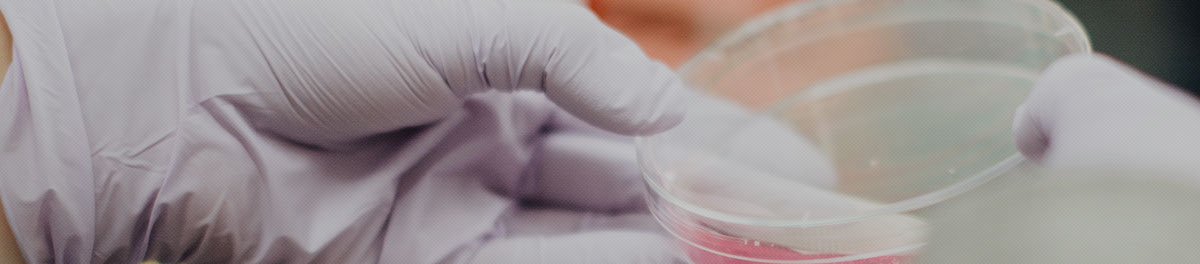

연구소소개
- 대진이화주식회사 부설 기술연구소는 다변화와 고품질화해가는 시장의 요구에 부응하기 위해 1998년 설립되었습니다. 광범위한 폴리우레탄소재의 응용성을 이해하고 깊이있는 연구를 위해 언제나 최선을 다하고 있으며 기술개발을 통한 소비자의 요구에 언제나 한발앞서 나가기 위해 노력하고 있습니다.
- 연질폴리우레탄시스템부터 경질폴리우레탄시스템까지 총망라한 종합우레탄회사의 연구소로서 각분야별 분업화된 연구파트를 통해 효율성을 극대화시키고 엄격한 품질관리와 사후관리를 통해 고객요구를 만족시킬 수 있도록 하고 있습니다.
- 폴리우레탄 난연성부가 및 환경문제극복을 위해 열심히 노력하고 있으며 고기능성 고부가가치의 제품개발을 위해 최선을 다하겠습니다. 폴리우레탄관련 궁금한 사항이나 개발과 관련하여 기술연구소에 연락을 주시면 성심성의껏 답변드리겠습니다.
주요개발실적
- 1.정형외과용 경질 폴리우레탄 폼 및 이의 제조방법(특허출원)1999년
- 2.정형외과용 콜셋(실용실안등록)1999년
- 3.영구압축줄음율(COM. SET)개선 필터원료개발2001년
- 4.RIM SPRAY코팅용 원료개발2002년
- 5.고난연성 PIR폼 개발 2003년
- 6.오일필터용 폴리우레탄원료개발 2004년
- 7.난연스프레이폼 개발 2004년
- 8.스폰지용 연질폼 원료 개발2005년
- 9.수성 연질스프레이 폼 개발2008년
- 10. 알루미늄샷시용 단열재 개발2013년
- 11.방화문용 1액형 난연 접착제 개발2014년
- 12.실링제용 폼 개발2017년







